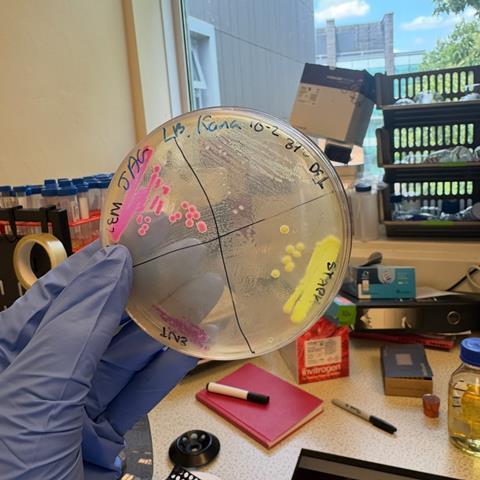
IMG_9660

Lucy Ella Malvern reports back on her AMI-sponsored summer studentship which investigated microbiome assembly in mosquitoes across developmental stages.
Lucy, from Billinge, Merseyside, is a biomedical science graduate from Keele University and did her studentship at Keele University, working alongside Dr Shivanand Hedge to help with the developing issue of vector borne diseases, specially in tropical and sup-tropical regions.

In order to help prevent the spread of vector borne diseases, this summer project aimed to expand our understanding of microbiome assembly in mosquitoes across developmental stages using a gnotobiotic rearing approach. The project assessed gut colonisation dynamics and inter-microbial interactions by creating a synthetic microbial community composed of uniquely labelled bacterial strains, each tagged with chromoprotein expressing plasmids for visual differentiation.
Gnotobiotic mosquito rearing allowed precise manipulation of microbiome composition, enabling investigation of how individual bacterial strains interact within the microbiome at different stages of a mosquito’s life cycle.
The aim is that by utilising this approach, it would provide insight into the mosquito microbiome interactions at different life stages which could be manipulated to reduce the spread of mosquito-borne diseases, thereby reduce mortality rates due to these diseases.I was able to create a synthetic community (SC) by modifying the bacterial microbiome.
Library of tagged bacteria
I have created a library of tagged bacteria expressing chromoprotein. I have also tested some of these SCs in the mosquito to track the infection.
I was surprised by the fact that we can use simple and classical microbiological techniques to answer questions on the role of the microbiome in host biology and disease transmission.

My work involves using novel approaches to study and control mosquito-borne diseases (VBD). I am trying to create a synthetic microbiome that can have a profound effect on mosquito biology and their ability to transmit the pathogens to humans. Ultimately, these will have an impact on the burden of the diseases in the endemic country and could able to reduce their incidence.
After finishing this research grant, I will begin my position at WHH in the pathology laboratory as a microbiology medical laboratory technician. I am forever grateful to have completed this research as it has provided me with key laboratory skills which are essential for the next stages of my career, and also highlighted the importance of utilising aseptic techniques within a lab, which, again, is vital within a diagnostic NHS laboratory.

Least favourite job in the lab?! I have loved all aspects of working in the lab, from streaking plates and creating overnight cultures, to autoclaving and organising the lab. However, I would say my least favourite part is the maths side of research as I believe it is the least interesting, even though the most important!
Find out more about AMI’s grants.
Topics
- Applied Microbiology International
- Bacteria
- Community
- Early Career Research
- gnotobiotic rearing
- Healthy Land
- host biology
- Infection Prevention & Control
- Keele University
- microbiome assembly
- mosquitoes
- One Health
- Shivanand Hedge
- Synthetic Biology
- UK & Rest of Europe
- vector-borne disease
- Veterinary Medicine & Zoonoses
- WHH
No comments yet